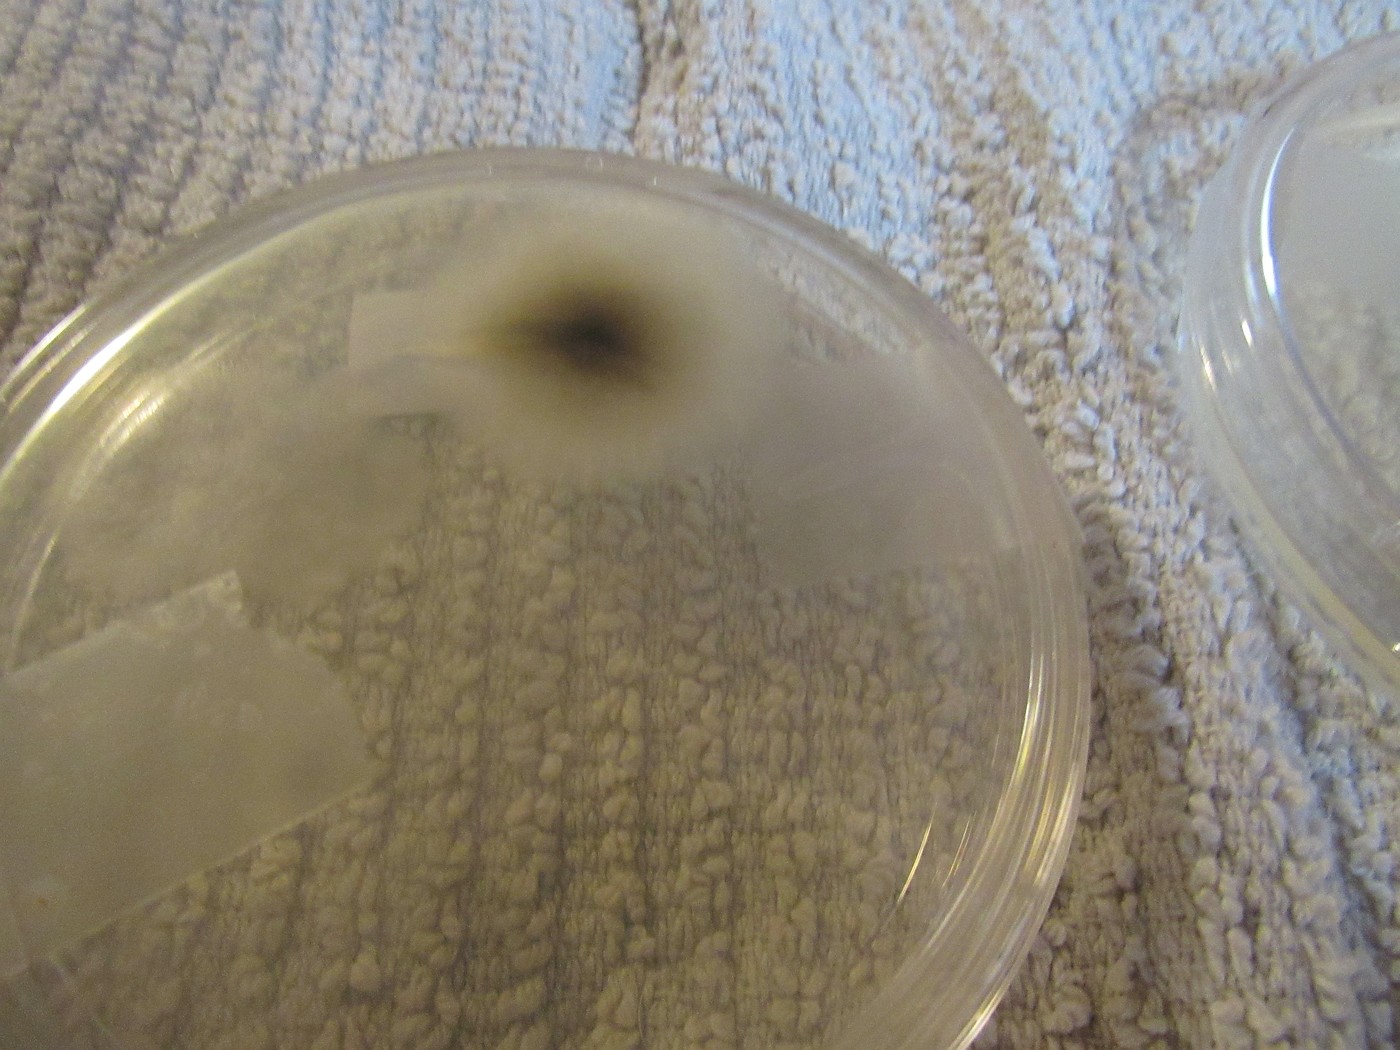
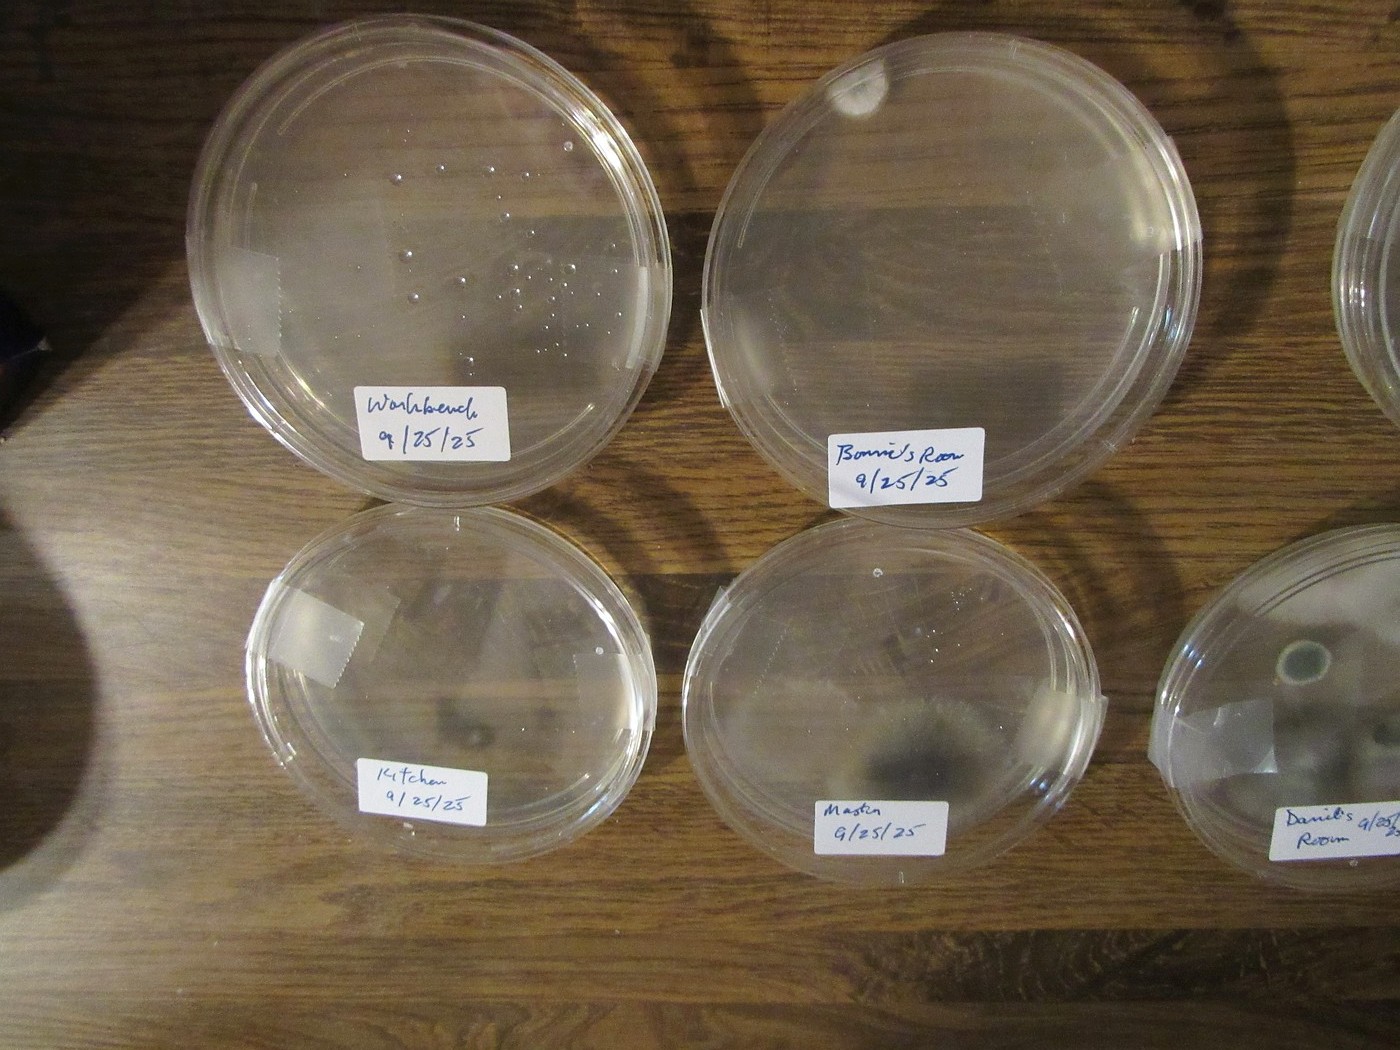
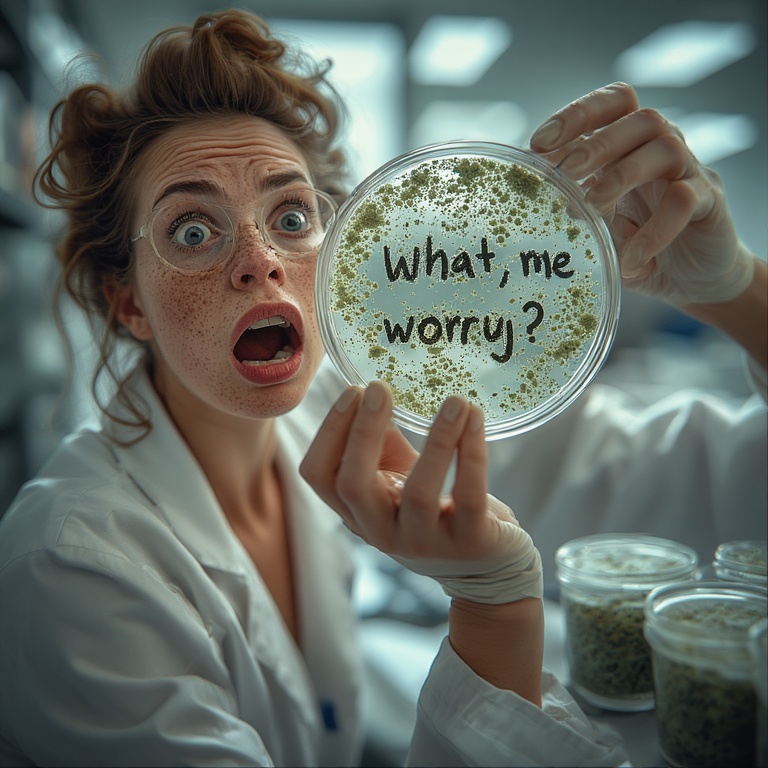
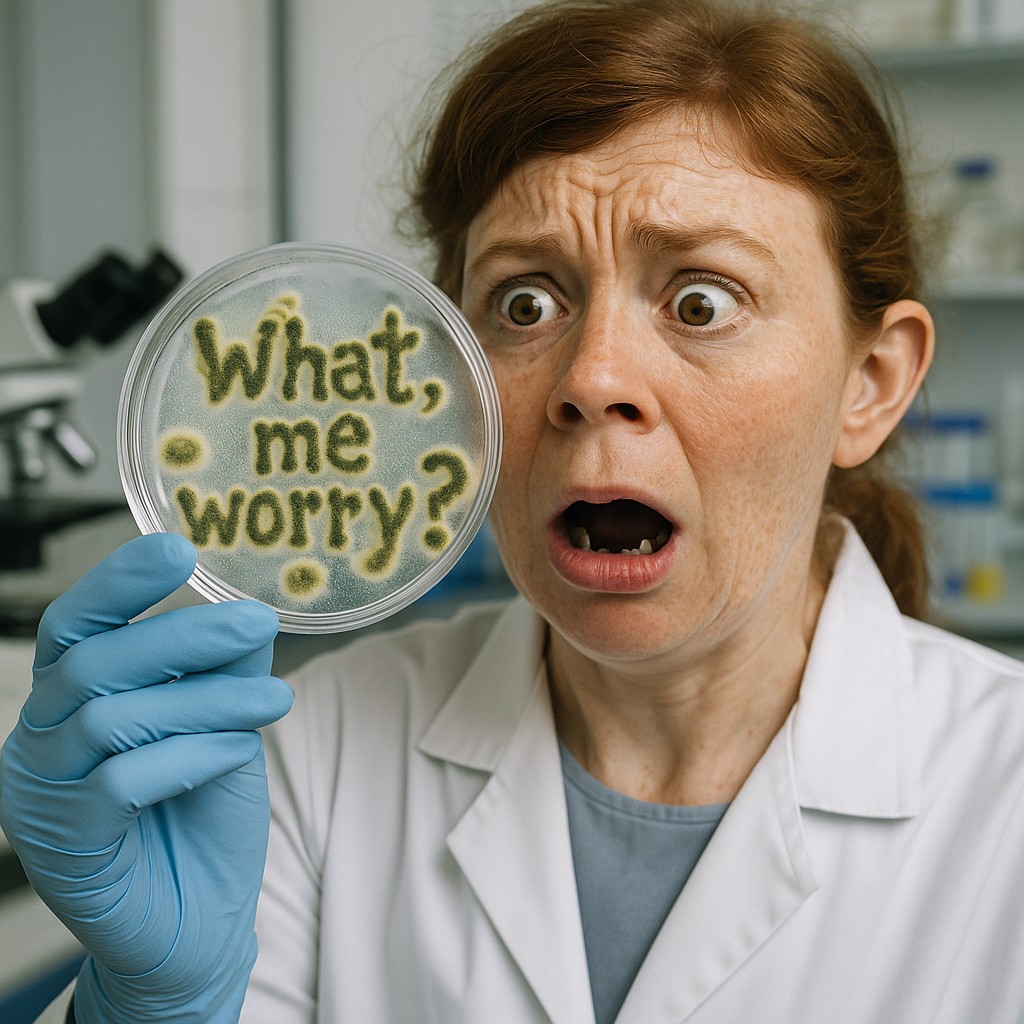
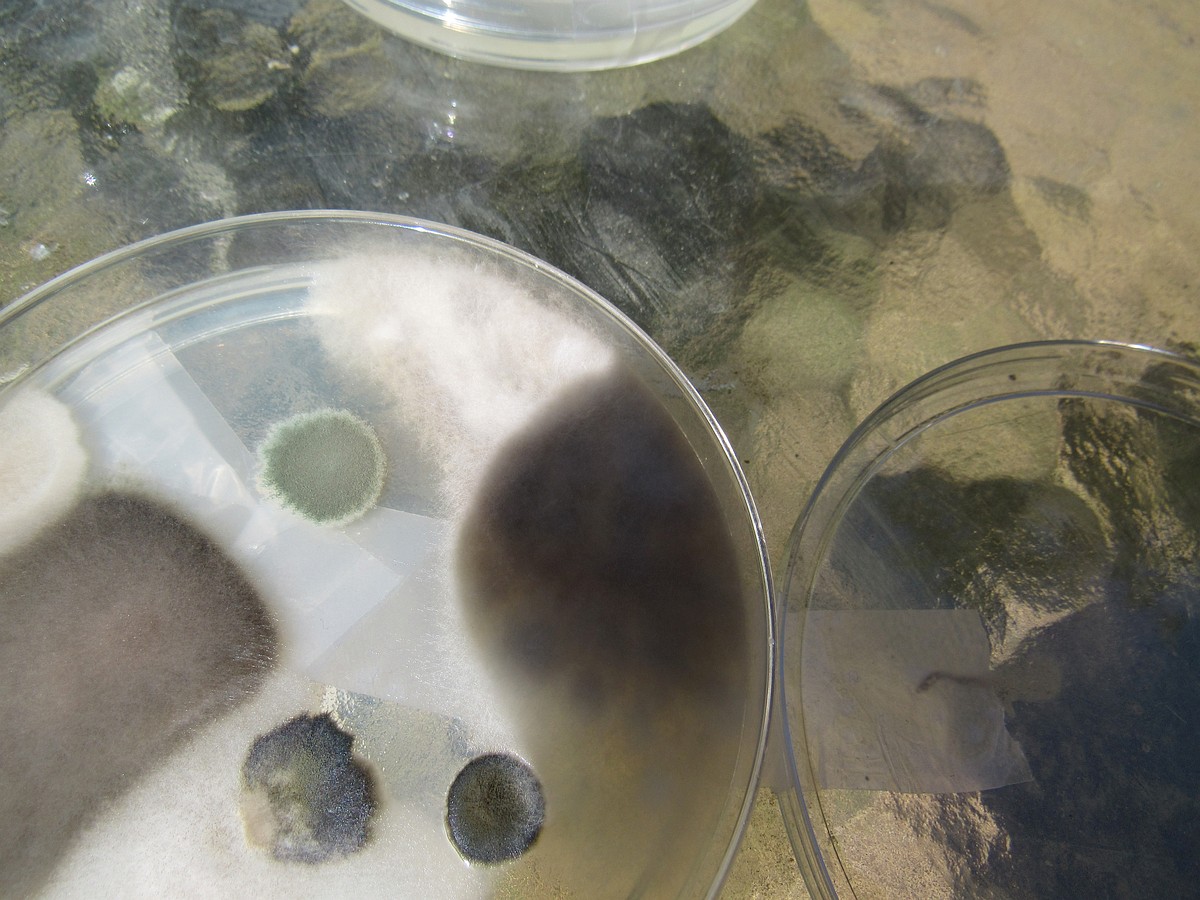
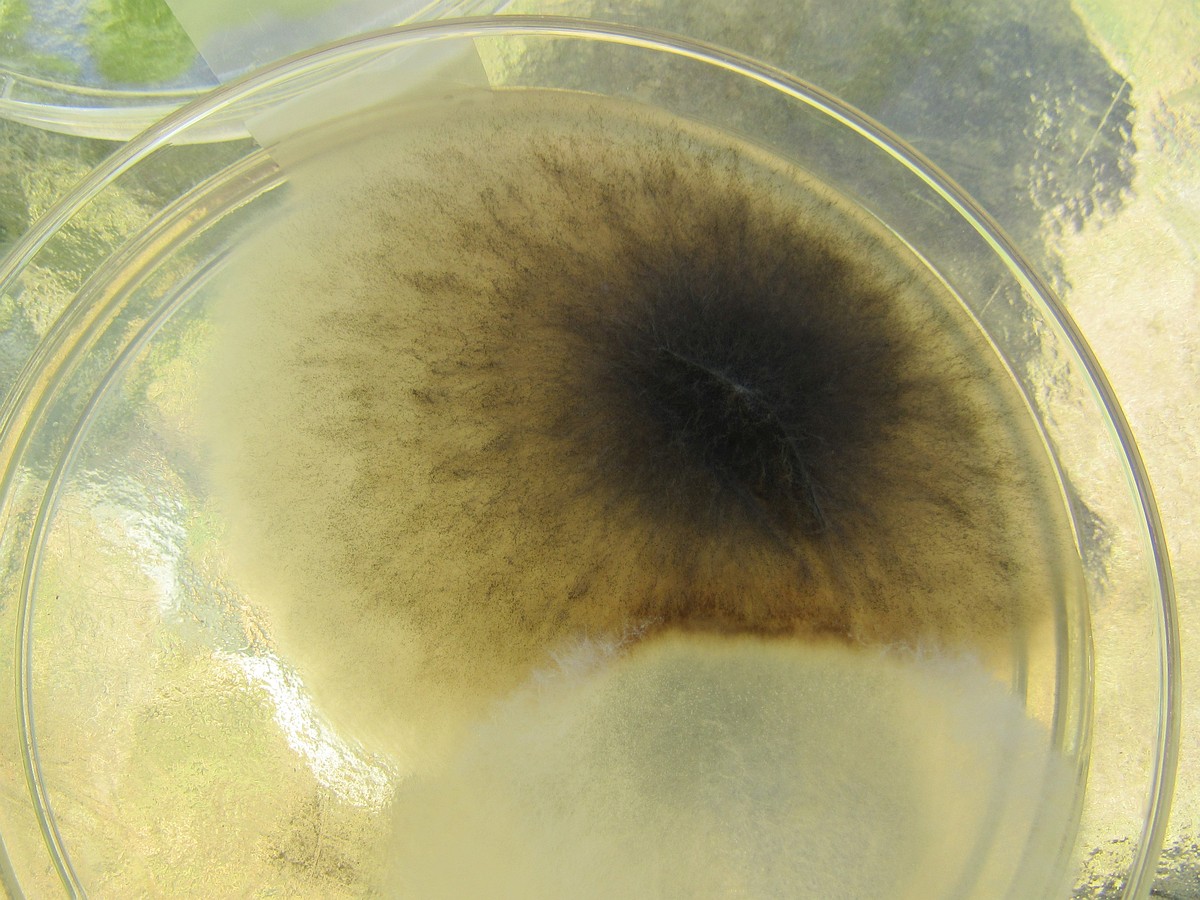
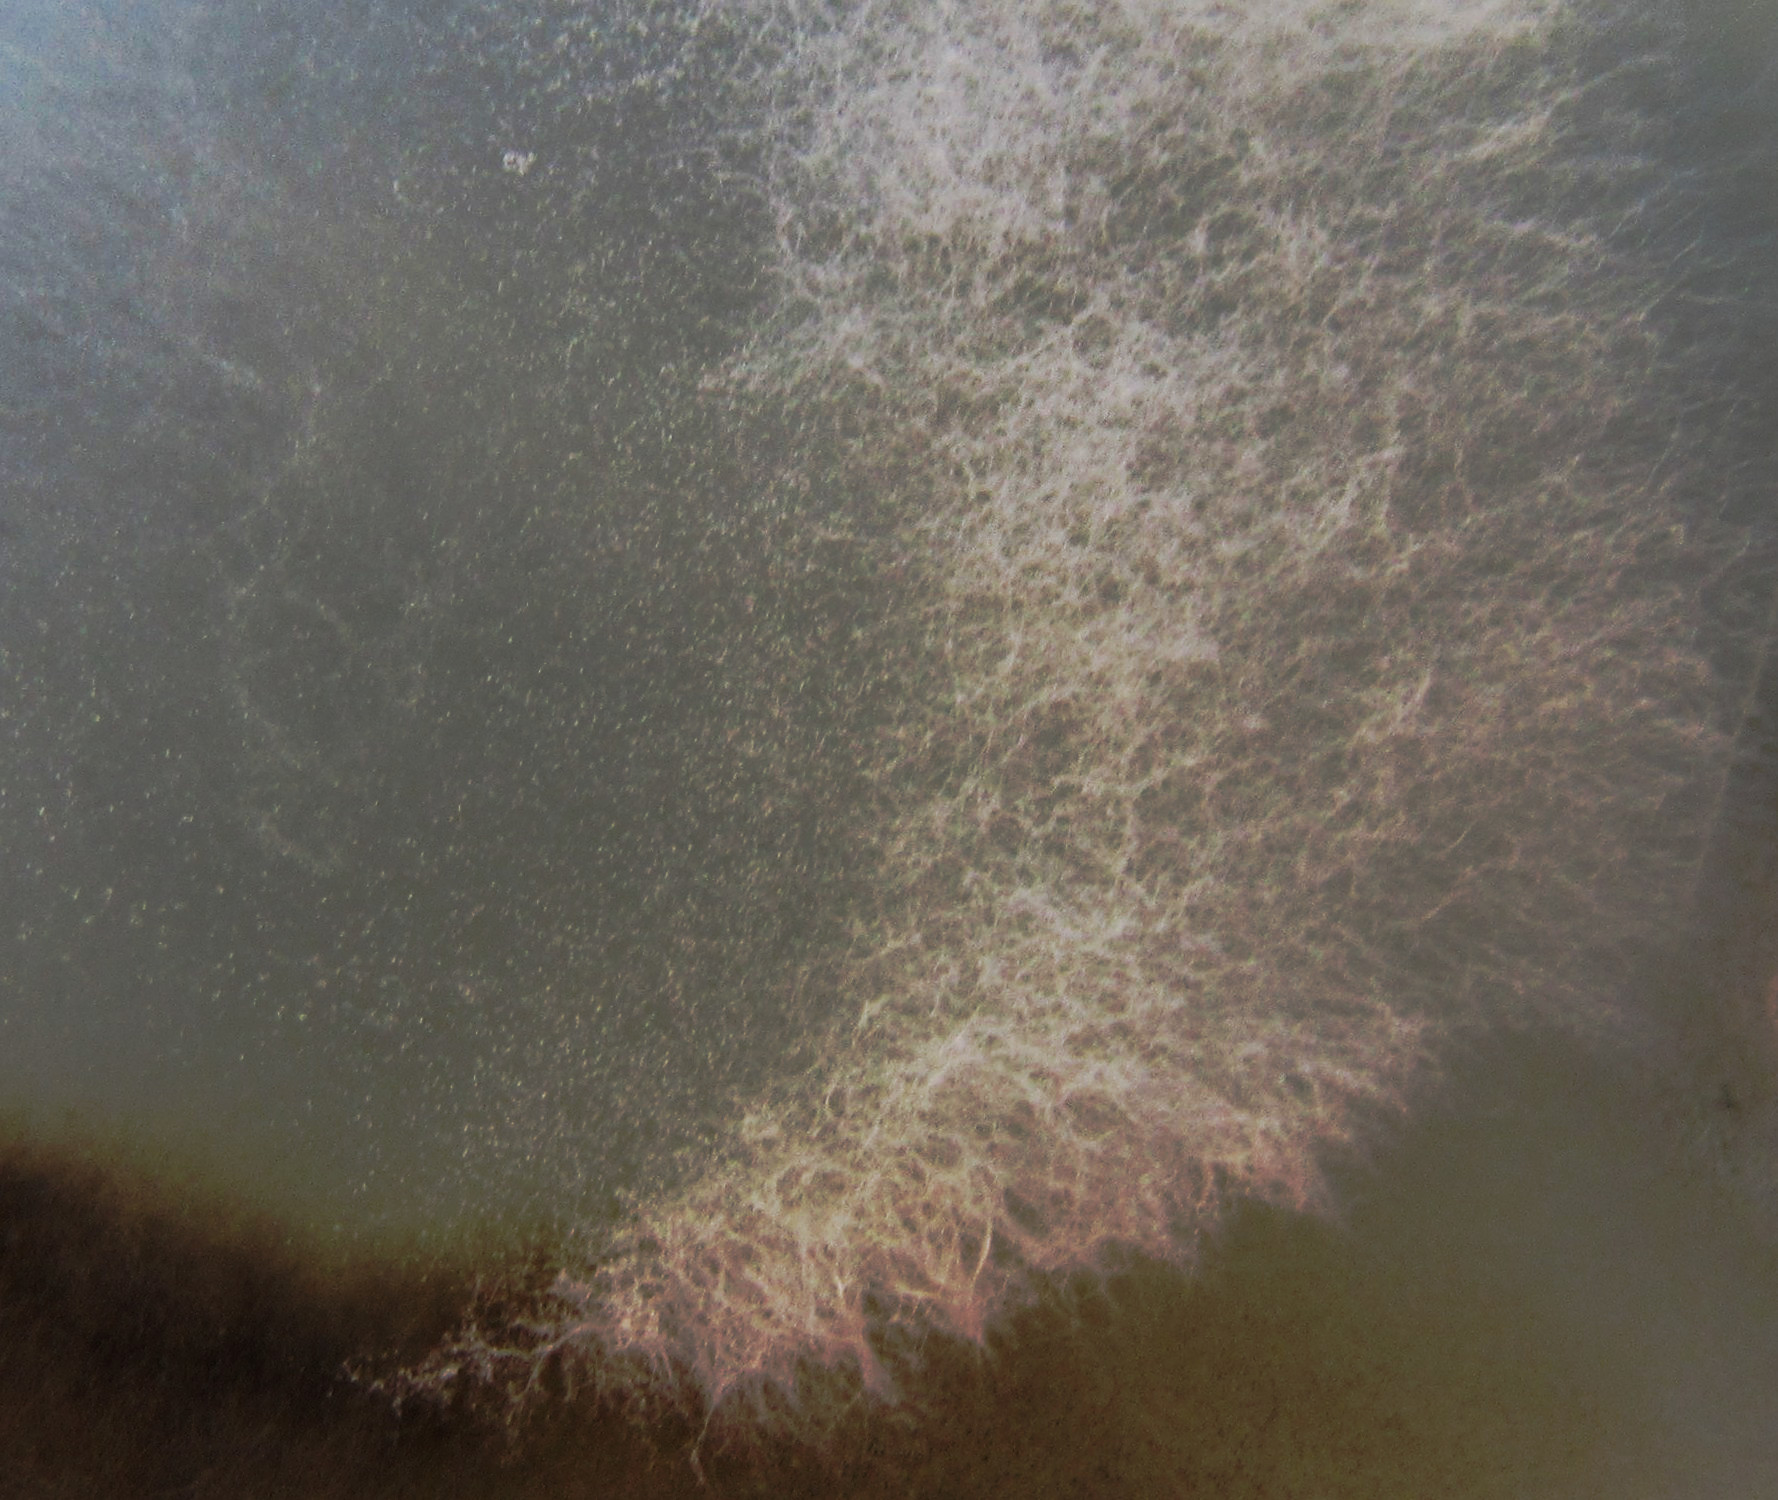
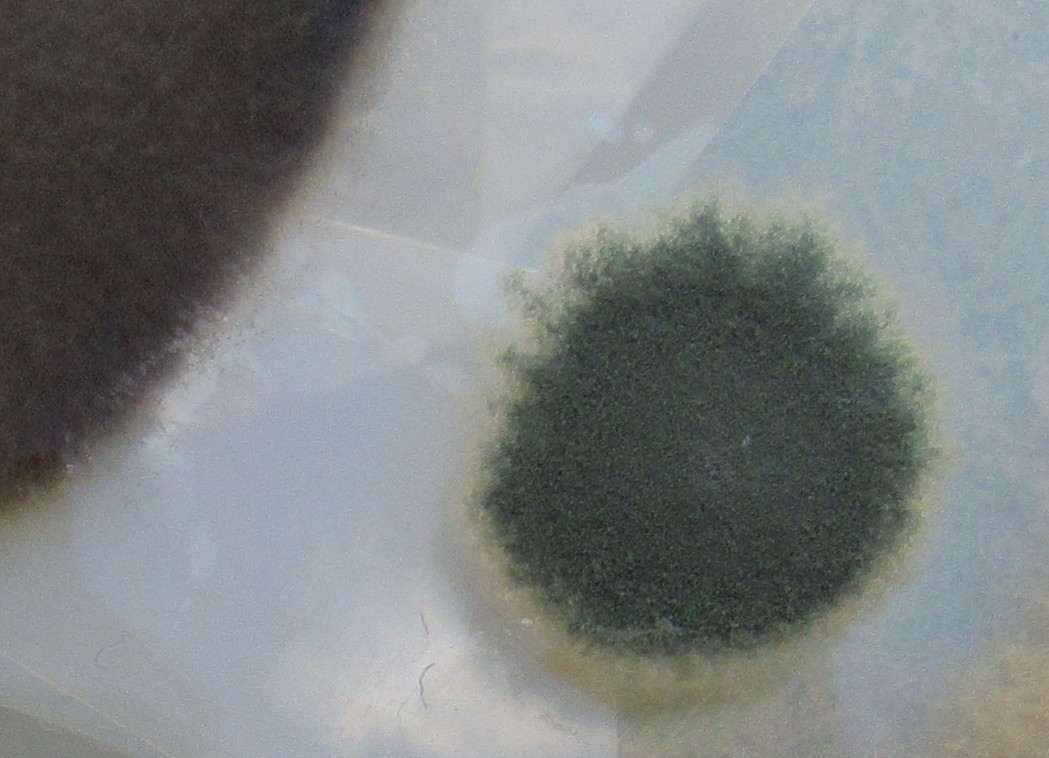
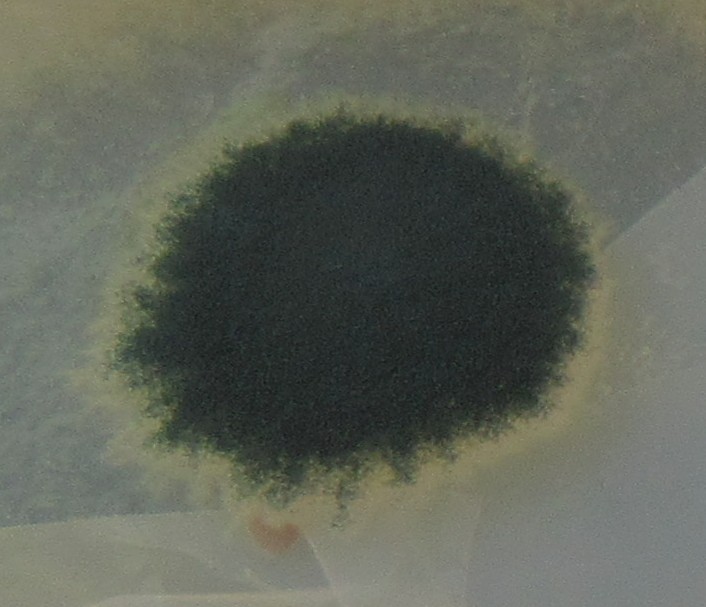

Austin is mold-friendly: warm and humid, and proximity to the State Capitol offers plenty of decaying organic matter. It’s basically a spore spa.

To satisfy the absolute minimum OSHA requirements, we placed DIY mold test Petri dishes in various locations of the sprawling WLBOTT campus.



And we waited….

Lab Results
Some disturbing results from the lab….

14 Days Later
Well past the 5-day incubation period….

But there is beauty, and with WLBOTT Fine-ish Art Museum has a moldy gallery.
Exhibit 7719-02

Exhibit 7717-01

Exhibit 7715-01






Exhibit 7711-01